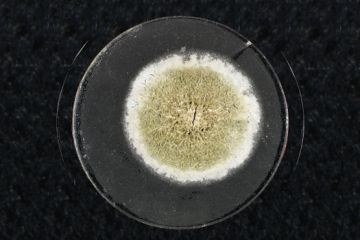

Boston College dispute moves to appeals court
A transatlantic wrangle over whether material collected in an oral history project can be used as evidence in a criminal investigation has moved to a US appeals court.
A transatlantic wrangle over whether material collected in an oral history project can be used as evidence in a criminal investigation has moved to a US appeals court.
Council for Assisting Refugee AcademicsStephen WordsworthThe Council for Assisting Refugee Academics (Cara) has named the former British ambassador to Serbia as its executive director. Stephen...
London School of Hygiene and Tropical MedicineLess is moreScientists have identified a gene that reduces the risk of younger women contracting breast cancer by lowering their oestrogen levels. A...

There’s more to the ancient world than dusty toff-on-toff talk, ‘professor of bloody Classics’ tells Matthew Reisz

Calls to thin RCUK ranks point to coordinated benefits of slimline solutions. Paul Jump reports

For the late Julia Swindells, radicalism and friendship were always intimately linked. Here, she describes the youthful influences that led her down a political path
When higher education ministers from 47 countries of the European continent meet in Bucharest on 26- April to pronounce on the next steps for the Bologna Process and the construction of the European...
A weekly look over the shoulders of our scholar-reviewers

Weekly transmissions from the blogosphere
• Sociology featured heavily in most media outlets this week, although it was down to research showing that stripping skills are on the slide because of the recession. Researchers at the University...

Alan Ryan on the faith in education that inspired ‘Great Books’ collections

Stitched up - New student-visa pattern required for a government that has lost the thread

Freely accessed papers are simply points in a constellation of scientific communication with the public, says Alice Bell
It's no trick: removing sector-sponsored overseas students from net migration data would be in the national interest
This sample comes from the laboratory where Sir Alexander Fleming (1881-1955) left a number of glass plates coated with bacteria overnight in 1928. It was this that led him to stumble upon the...